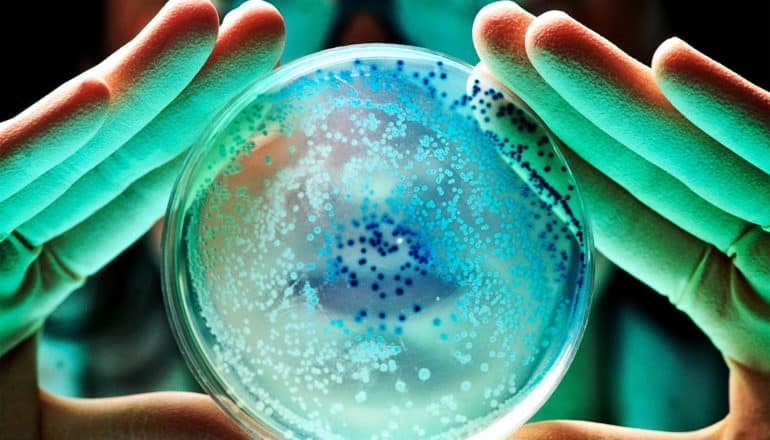

Computer algorithms can determine antimicrobial resistance of bacteria faster than previous methods, researchers report.
This could help treat serious infections more efficiently in the future.
Antibiotic-resistant bacteria are on the rise all over the world. Each year, infections caused by multi-drug resistant bacteria lead to at least 300 fatalities in Switzerland alone.
Rapid diagnostic testing and the targeted use of antibiotics play a crucial role in curbing the spread of these antibiotic-resistant “superbugs.”
However, it often takes two or more days to determine which antibiotics are still effective against a particular pathogen because the bacteria from the patient’s sample first have to be cultivated in the diagnostic lab.
Due to this delay, many doctors initially treat serious infections with a class of drugs known as broad-spectrum antibiotics, which are effective against a broad range of bacterial species.
Now, researchers have developed a method that uses mass spectrometry data to identify signs of antibiotic resistance in bacteria up to 24 hours earlier.
“Intelligent computer algorithms search the data for patterns that distinguish resistant bacteria from those that are responsive to antibiotics,” says Caroline Weis, a doctoral student in the biosystems science and engineering department at ETH Zurich and lead author of the study in the journal Nature Medicine.
By identifying significant antibiotic resistances at an early stage, doctors can tailor an antibiotic therapy to the relevant bacterium more quickly. This can be particularly beneficial for seriously ill patients.
“The time taken to optimize antibiotic therapy might mean the difference between life and death if an infection is serious,” says Adrian Egli, professor and head of clinical bacteriology at the University Hospital Basel. “A fast, accurate diagnosis is extremely important in those kinds of cases.”
800 bacteria and 40 antibiotics
The mass spectrometry instrument that supplies the data for the new method is already in use at many microbiology labs worldwide to identify bacterial types. The device analyzes thousands of protein fragments in each sample and then creates an individual fingerprint of the bacterial proteins. This process also requires bacteria to be cultured beforehand, but only for a few hours rather than a few days.
The researchers in Basel have developed a new method that extends the uses of mass spectrometry to include the identification of antibiotic resistance. For this dataset, the teams extracted more than 300,000 mass spectra of individual bacteria from four laboratories in North-Western Switzerland and linked these to the results of the corresponding clinical resistance tests. The result is a new, publicly available dataset covering around 800 different bacteria and over 40 different antibiotics.
“Our next step was to train artificial intelligence algorithms with this data such that they could learn to detect antibiotic resistance on their own,” says Karsten Borgwardt, professor in the biosystems science and engineering department at ETH Zurich in Basel, who led the study with Egli.
In order to make their predictive model as widely applicable as possible, the researchers analyzed how the training data influenced the algorithm’s performance. The different approaches compared in the study included training the predictive model with data from just one hospital and training with data combined from multiple hospitals.
While previous studies in this field of research have focused on individual bacterial species or antibiotics, the new study draws on several bacterial types isolated in hospitals as well as a multitude of associated resistance characteristics.
“Our dataset is the largest to date to combine mass spectrometry data with information on antibiotic resistance,” Borgwardt says. “It’s a great example of how existing clinical data can be used to generate new knowledge.”
Antibiotic resistance in hospitals
To gauge the usefulness of the computer predictions, the researchers teamed up with an infectious diseases expert to analyze around 60 case studies. Their goal was to determine the extent to which the predictions would have influenced the choice of antibiotic therapy if they had been available to the clinician at an early stage in the decision-making process.
The research team deliberately chose case studies featuring the most important antibiotic-resistant bacteria, including methicillin-resistant Staphylococcus aureus (MRSA) and gut bacteria resistant to broad-spectrum beta-lactam antibiotics (E. coli).
One reason this case study is so important is that doctors also tend to base their choice of antibiotic on factors such as a patient’s age and medical history. The results showed that the new method would indeed have prompted the clinician to opt for an improved antibiotic therapy in some cases.
Before the new diagnostic method can be implemented in patient care, the team will need to overcome additional challenges, which include the implementation of a large-scale clinical trial to corroborate the benefits of the new method in a routine hospital setting.
“The planning for such a study is already underway,” Egli says. As an expert in clinical microbiology, he is confident that the project will improve how infections are treated over the next few years.
The project also raises many important research questions concerning the use of artificial intelligence in medicine, Borgwardt says.
“This dataset allows us to take a closer look at the changes we need to make at the algorithmic level to further enhance the quality of predictions for data gathered at different points in time and at different locations.”
Support for this work came from the two Cantons of Basel through a D-BSSE-Uni-Basel Personalized Medicine grant from the ETH Zurich.
Source: Rahel Künzler for ETH Zurich
The post AI spots antibiotic resistance 24 hours faster than old methods appeared first on Futurity.
from Futurity https://ift.tt/3GEeqPx
No comments:
Post a Comment